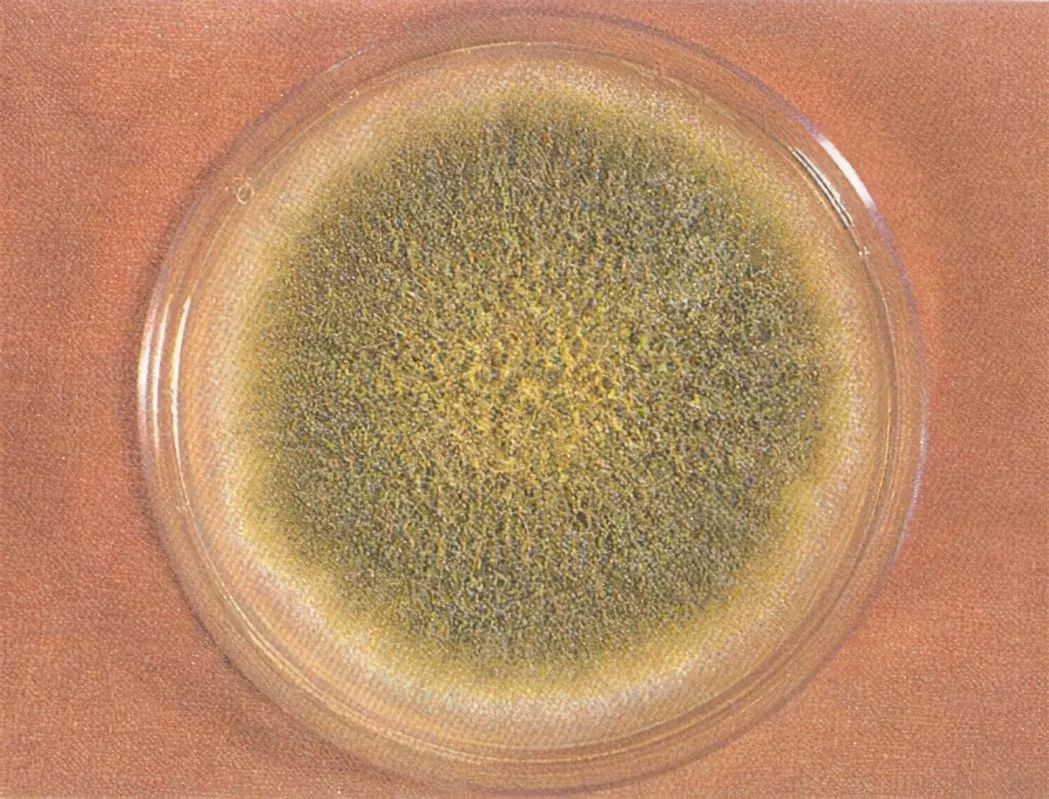

审核专家:顾
海彤 首都医科大学北京同仁医院呼吸内科副主任医师

“黄梅时节家家雨,青草池塘处处蛙”,每年的六、七月份,我国的长江中下**游地区,**都要面临一个难题——如何熬过湿哒哒的天气。

来源|pexels
在这样湿热的环境下,脱掉的衣服如果没有及时清洗,等到过两天再拿出来时,可能上面已经布满了霉点;还有你刚买回来的零食面包,】‘
因为没有彻底封上口子,只需要一个下午,它就有可能变质了;甚至霉菌已经强大到连卫生间的瓷砖、不怎么被注意的墙角等等都会留下它的印记。
来源|pixabay

毋庸置疑,此时霉菌已经侵入你的家里并且落地生根了!
霉菌是什么
霉菌泛指能在食物、墙壁等物体表面形成一层肉眼可见的菌丝体及孢子,而不能形成肉眼可见的子实体的丝状真菌。在干燥的环境下,霉菌只是飘在空气中,活性较低,但是一旦遇到水,它就瞬间活了过来,并且会不断生长繁殖。总而言之,霉菌喜欢生长在潮湿温暖的地方。
来源|unsplash

家里的很多家具用品,例如木质类的桌椅、柜子,墙纸、铺在地上的地毯、还有我们穿在身上的棉织物等都能够为霉菌提供养分,帮助霉菌安家落户。根据研究统计,当湿度大于65%,温度处在10℃到32℃之间时,在有机质作为生长的营养基础下,霉菌孢子就快活起来了,它会快速长出菌丝或者分支,在霉菌生长的同时,还会散发出一种我们夏天非常熟悉的味道——霉味,它是一种具有挥发性的有机物的气味。
霉菌的基内菌丝、气生菌丝和繁殖菌丝
来源|百度百科
霉菌是个“两面派”
别看霉菌看起来似乎微不足道,它的威力可非同一般。曾有统计环境中大约有300多种霉菌,部分霉菌的存在会对人类健康造成严重威胁。霉菌产生的大量孢子是已知的强过敏原,对霉菌过敏的人特别要注意哦。如果你身体最近出现了一些莫名其妙的过敏性问题如打喷嚏、咳嗽、流鼻涕、喉咙发痒等等,那就不得不考虑一下是不是因为居家环境中霉菌繁殖导致的了。霉菌和我们平常见到的细菌感染大不相同,霉菌是十分顽强的存在,一旦人不小心被感染了,治疗难度较大。
霉菌孢子
来源|百度百科
另外,一些霉菌的代谢产物具有毒性。就拿我们熟知的黄曲霉素来讲,黄曲霉素主要在发霉的食物中产生,是黄曲霉的代谢产物,像我们生活中吃的花生、核桃这些坚果类食品在适宜的温度和湿度下极其容易被感染而产生黄曲霉素,粮食如果没有及时晒干或者储藏不当也会产生黄曲霉素。黄曲霉素是一种致癌性极强的物质,大量食用含有黄曲霉素的食物会导致肝实质细胞大量坏死、肝出血等急性疾病,摄入一定量后甚至会出现死亡的情况。
图片来源 | 中国科普博览
所以,消除家中的霉菌是一件很有必要的事情!如果霉菌还没有在家中“肆意妄为”,那我们就不要给霉菌提供舒适的生长条件:通过使用除湿机避免环境过于潮湿,保持湿度在40%左右;对屋顶、管道漏水等问题及时修理,及时清理旧书、旧报纸;使用空气净化器,利用过滤膜“逮住”霉菌孢子等。
旧书长霉
来源|某购物网站
如果家里的霉菌已经形成,那也不用慌张,第一我们要做好自我防护,戴上口罩和橡胶手套;第二保护好尚未发霉的房间,关紧门窗;第三用家用清洁剂清洗霉点并用干净的自来水冲洗;第四用漂白剂进行杀菌处理并将物体表面烘干;第五打开空气净化器清理死去的霉菌和残余在空气中的霉菌;最后要记得处理好这些用过的工具并及时清洗双手。当然,我们生活中还是有不少对人类有帮助的霉菌,像很多家庭都特别爱吃的豆腐乳和豆豉就要利用到毛霉。还有人类发现和利用的第一个抗生素——青霉素,就是青霉产生的,时至今日它还在兢兢业业地为老百姓服务。再比如用来治虫的农药,便有白僵菌的身影,菌如其名,它可以产生毒素和抗生素使得昆虫感染后遍体生白毛,僵硬而死。诸如此类的霉菌兄弟在我们生活中还有很多,大家细心观察也能够发现哦!
豆腐乳表面的菌丝
来源 | 百度图片
霉菌无处不在,霉菌亦敌亦友,在我们这个缤纷多彩的世界里,我们同样也要理性地看待霉菌,不能一棒子打死,也不能掉以轻心。妥善合理地利用,进一步研究、发现和测定霉菌毒素,采取有效措施控制有害霉菌的活动,才能更好地保障人民健康、发展农牧事业、防治环境污染等。




 扫码下载APP
扫码下载APP

 科普中国APP
科普中国APP
 科普中国
科普中国
 科普中国
科普中国